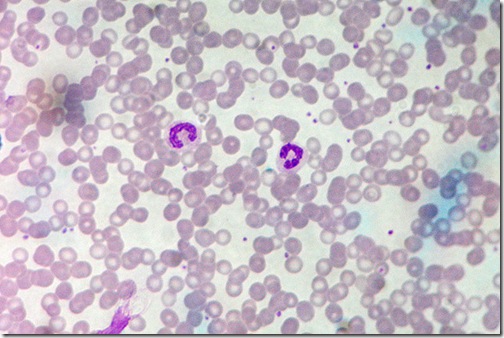

Patógeno provoca que la planta libere sustancias que atraen a los insectos que lo transportan.
Los insectos que transportan agentes infecciosos causantes de enfermedades se llaman vectores. Por ejemplo: el vector de la malaria es un mosquito conocido como Anopheles gambiae, el vector de la enfermedad de Chagas es la chirimacha, mientras que el vector del dengue es otro mosquito llamado Aedes aegypti.
Al igual que nosotros, las plantas también sufren de enfermedades causadas por virus, bacterias, hongos y protozoarios, que son transmitidos por insectos. Un grupo de investigadores de la Universidad de Florida, liderados por el Dr. Lukasz Stelinski, han demostrado experimentalmente los mecanismos que usa una bacteria patógena llamada Candidatus Liberibacter asiaticus (CLas) para inducir en la planta un comportamiento que atrae a sus vectores. El estudio aparece publicado en PLoS Pathogens.
Las bacterias CLas atacan a los cítricos como el limón, la naranja y la mandarina provocándoles una devastadora enfermedad conocida como huanglongbing (HLB o “Enfermedad del Dragón Amarillo”, por su traducción del chino). Cuando lo hacen, se alojan en el floema de estas plantas robándoles todos sus nutrientes. Su vector es un diminuto piojo saltarín conocido como el psílido asiático.
Stelinski y su equipo descubrieron que cuando la planta está infectada por la bacteria libera una sustancia química volátil llamada salicilato de metilo, la cual ejerce un “efecto AXE” sobre los psílidos. En otras palabras, las plantas infectadas por la bacteria son más atractivas para los vectores que las no infectadas.
Los insectos que se posan sobre las plantas enfermas se llevan una gran decepción al ver que estas no son muy nutritivas: las bacterias provocan que los niveles de nitrógeno, fósforo, azufre, zinc y hierro se reduzcan considerablemente. Para su mala suerte, cuando se dan cuenta de ello ya es demasiado tarde, los patógenos ya se alojaron en su cuerpo como si fueran unos polizontes y se mantienen allí a la espera de que el vector se pose sobre otra planta sana para poder infectarla.
De esta manera, la bacteria inicia un nuevo ciclo de manipulación fisiológica del cítrico para atraer a sus vectores y facilitar su proliferación. Y este no es el único caso. Otra bacteria conocida como fitoplasma bloquea la expresión de una hormona vegetal llamada jasmonato, la cual protege a las plantas del ataque de los insectos, promoviendo así la fecundidad de su vector.
Referencia:
Mann, R., Ali, J., Hermann, S., Tiwari, S., Pelz-Stelinski, K., Alborn, H., & Stelinski, L. (2012). Induced Release of a Plant-Defense Volatile ‘Deceptively’ Attracts Insect Vectors to Plants Infected with a Bacterial Pathogen PLoS Pathogens, 8 (3) DOI: 10.1371/journal.ppat.1002610
Imagen | http://www.entomol.ntu.edu.tw/english/html/chen.htm






















![megavirus[5] megavirus[5]](https://blogger.googleusercontent.com/img/b/R29vZ2xl/AVvXsEj9YbyHdoF5ZeMhcPvNlG3eHzHGLV2Krlr8SSSXhXW-MRZ_VTrXjFkN7_HlyzDWVuZ79ccKcJbl0LQdHQv8gjvBObfauLZexbJx-1muQY8090il7v8DPdN3GVNs5C3-8wiBgoYe/?imgmax=800)